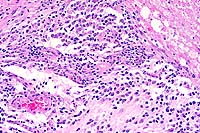

Results
AFIP Wednesday Slide Conference - No. 6
7 October 1998
- Conference Moderator:
Dr. John Pletcher, Diplomate, ACVP
Pathology Associates International
15 Worman's Mill Court
Frederick, MD 21701
-
- NOTE: Click on images for larger views. Use
browser's "Back" button to return to this page.
Return to WSC Case Menu
-
- Case I - 98-040 (AFIP 2638214)
-
- Signalment: Two-year-old, castrated male, Labrador
Retriever mixed breed dog.
-
- History: This dog had a one month history of progressive
left hemiparesis. The dog was short-strided in the left foreleg
and long-strided in the left rear leg. Neurologic examination
was consistent with C6-T2 left-sided myelopathy.
-
- Laboratory Results: A myelogram demonstrated an intradural
mass at C7-T1.
-
- Gross Pathology: A 4x4x1cm, irregularly shaped mass
was present within the left cranial thoracic cavity. The mass
thickened the spinal nerves C7, C8, and T1 leading into it, and
thickened the peripheral nerves branching caudal and ventral
into the thoracic cavity. On cut section, the spinal cord contained
a gray intramedullary mass extending from C7-T1.

- Case 6-1. Gross photo. Adjacent to the excised spinal
cord there is a hemorrhagic, multinodular mass (5x9cm) attached
to and surrounding 3-4 spinal nerves. This mass encompasses another
longitudinally oriented structure which may represent another
nerve or a large blood vessel (aorta?).
-
- Contributor's Diagnosis and Comments: Primitive neuroectodermal
tumor involving the cervical spinal cord and left brachial plexus.
-
- Primitive neuroectodermal tumors (PNETs) are embryonal tumors
of the nervous system that have been extensively described in
children and less so in domestic animals. Medulloblastomas have
been reported in the baboon, the dog, the mouse, and the cow.
A PNET has been recently reported in a colobus monkey. Historically,
PNETs occurring in the cerebellum have been referred to as medulloblastomas.
The term medulloblastoma continues to be used specifically for
PNETs that occur in the cerebellum; however, the term PNET emphasizes
the primitive, undifferentiated phenotype of the cells in these
tumors. PNETs are composed of sheets of round to oval to short
spindle cells which, in the dog, rarely form rosettes. By immunohistochemical
methods, the cells may have evidence of differentiation along
neuronal, ependymal, or glial cell lines. In our experience,
these tumors in the dog are often very primitive, and in formalin-fixed
specimens may only have rare cells positive for GFAP, neurofilament,
or synaptophysin.
 2x
obj
2x
obj 20x
obj
20x
obj
- Case 6-1. Spinal cord. This section (2x obj)
of spinal cord is expanded and replaced by an infiltrative mass
supported by a prominant fibrovascular stroma. Tumor cells are
quite pleomorphic, and characterized by oval to round cells which
may be closely associated or individualized, and include scattered
elongated cells separating the neuropil. Nuclei are hyperchromatic.
-
- AFIP Diagnosis: Spinal cord: Primitive neuroectodermal
tumor, Labrador Retriever mixed breed, canine.
-
- Conference Note: The tumor histomorphology is consistent
with a primitive neuroectodermal tumor (PNET) and may represent
a primary tumor within the spinal cord, extension of a peripheral
PNET from spinal nerve roots into the spinal cord, or metastasis
from a primary brain tumor. The tumor is composed of a dense,
monomorphic population of small polygonal to spindled cells that
blend into the overlying meninges, separate and surround spinal
nerves, and compress and infiltrate the spinal cord parenchyma.
While infiltrative, the tumor is well delineated from the adjacent
preexisting neuropil. Neoplastic cells occasionally appear round
due to artifactual separation of the tumor and neuropil. Tumor
cells have indistinct cell borders with scant to small amounts
of eosinophilic cytoplasm and hyperchromatic nuclei that are
round to elongate and contain indistinct nucleoli. Occasionally,
neoplastic cells contain eccentrically placed nuclei that are
rounded on one end and taper at the opposite end with small amounts
of trailing eosinophilic cytoplasm ("carrot-shaped"
cells). There are rare rosettes.
-
- Immunohistochemical studies performed at the AFIP demonstrate
that the tumor is diffusely positive for synaptophysin, multifocally
positive for glial fibrillary acidic protein (GFAP), and diffusely
negative for neurofilament protein (NFP) and neuron specific
enolase (NSE). The immunohistochemical results are consistent
with those reported for PNET's of humans and animals. PNET's
are usually positive for synaptophysin, and may be multifocally
GFAP and/or NFP positive, demonstrating bipotential differentiation
of these primitive tumors. Astrocytomas, which should be considered
in the differential diagnosis for PNET, often have extensive
GFAP positivity, but are consistently negative for synaptophysin
in humans.
-
- Differential diagnosis discussed by conference attendees
based on location and histomorphology included astrocytoma and
lymphoma. Astrocytomas often arise in the piriform lobe and brain
stem and tend to blend with the adjacent neuropil, while the
tumor in this dog is fairly well-demarcated. The neoplastic neuroglial
cells in astrocytomas often occur within a background of lightly
eosinophilic fibrillar material and are usually more differentiated,
though poorly differentiated astrocytomas may be difficult to
distinguish from PNET without the aid of immunohistochemical
markers. Lymphoma was considered based upon the individualization
of some tumor cells, but the compressive nature of the neoplasm
and cytomorphology suggest a cohesive rather than a discrete
cell neoplasm of hematopoietic origin.
-
- Contributor: University of Pennsylvania, The School
of Veterinary Medicine, Department of Pathobiology, 3800 Spruce
St., Philadelphia, PA 19104.
References:
- 1. Molenaar W, Trojanowski J: Primitive neuroectodermal tumors
of the central
nervous system in childhood: Tumor biological aspects. Crit Rev
Onc Hematol 17:1-25, 1994.
- 2. Berthe J, Barneon G, Richer G, Mazue G: A medulloblastoma
in a baboon (Papio papio). Lab Anim Sci 30:703-705, 1980.
- 3. Jolly RD, Alley MR: Medulloblastoma in calves. Path Vet
6:463-468, 1969.
- 4. Long PH, Schulman FY, Koestner A, Fix AS, Campbell MK,
Cameron KN: Primitive neuroectodermal tumor in a two-month-old
black and white colobus monkey. Vet Pathol 35:64-67, 1998.
- 5. Summers BS: Tumors of the central nervous system. In:
Veterinary Neuropathology, pp.375-379, Mosby-Year Book Inc.,
St. Louis, MO, 1995.
- 6. Gould VE, et al.: Primitive neuroectodermal tumors of
the central nervous system: Patterns of expression of neuroendocrine
markers and all classes of intermediate filament proteins. Lab
Invest 62:498-509, 1990.
-
- Case II - 97N172 (AFIP 2638859)
-
- Signalment: Six-year-old, male, New Zealand white
rabbit, Oryctolagus cuniculi.
-
- History: This rabbit was used only for breeding on
a teratology study. No manipulations were performed on this rabbit.
-
- Gross Pathology: A pedunculated mass (18 x 10 x 10
mm) extended from the buccal mucosa of the left side of the mouth.
Laboratory Results: None.
-
- Contributor's Diagnosis and Comments: Odontogenic
neoplasm, buccal mucosa. Differential diagnosis includes an ameloblastic
odontoma and an inductive fibroameloblastoma.
-
- Epithelial odontogenic tumors can be classified into two
groups: those that lack inductive properties on connective tissue
and those that have inductive properties on connective tissue.
Ameloblastoma and calcifying epithelial odontogenic tumor are
considered noninductive. Ameloblastomas are characterized by
cords and islands of stellate reticulum with peripheral palisades
of polarized columnar cells. Calcifying epithelial odontogenic
tumor contains foci of Congo-red positive material surrounded
by pleomorphic polygonal cells.
-
- There are five tumors in which induction of mesenchymal tissue
is evident: ameloblastic fibroma (fibroameloblastoma), with characteristics
of ameloblastoma plus proliferation of closely associated pulp-like
mesenchyme; dentinoma consisting of masses of dentin, often with
minimal cellular component; ameloblastic odontoma which contains
palisaded epithelium and stellate reticulum as in ameloblastoma,
as well as foci of dentin and/or enamel; complex odontoma which
is a disorderly array of dentin, enamel, ameloblastic epithelium
and odontoblasts; and compound odontoma, containing denticles
with well-organized tooth morphology.
-
- These types have been reported in dogs, cats, cows, and a
vole, but not rabbits. Also, the location of this particular
tumor is unique. It appeared as a pedunculated mass arising from
the buccal mucosa, not from the mandible or maxilla.
 10x
obj
10x
obj
- Case 6-2. Oral mucosa. Beneath the mucosal epithelium
there is a multinodular mass lined by columnar epithelial cells
(arranged in palisades) which surround areas of loose stellate
reticulum. Occasional foci of mineralized debris and squamous
epithelial cells are found within epithelium lined cystic spaces.
-
- AFIP Diagnosis: Buccal mucosa: Ameloblastoma, New
Zealand white rabbit, lagomorph.
-
- Conference Note: The histomorphology of the tumor
is characterized by islands and anastomosing cords of epithelium
with peripheral palisades of tall columnar cells containing antibasilar
polarized nuclei (preameloblasts) that enclose large, central
areas of stellate reticulum. The columnar cells are separated
from the supportive collagenous stroma by a prominent, brightly
eosinophilic limiting membrane. Multifocally, there are nests
of keratinizing polygonal cells, occasionally containing small
fragments of mineral, which are interpreted as hyperplastic rete
ridges with entrapped epithelium.
-
- Conference participants agreed that this tumor represents
an odontogenic neoplasm. Additionally, most conference participants
interpreted this tumor as a noninductive odontogenic neoplasm
whose histomorphologic features are most consistent with ameloblastoma.
Although the location within the buccal mucosa is highly unusual
and difficult to explain, it may represent an ectopic rest of
odontogenic tissue. The delicate cellular stroma that resembles
the dental papilla and forms the characteristic mesenchymal component
of an ameloblastic fibroma is not identified. While stellate
reticulum may be present in ameloblastic fibroma, it usually
is not abundant or prominent. Additionally, material consistent
with enamel or dentin was not identified by conference participants.
-
- Epithelial odontogenic tumors are uncommon, poorly understood,
diagnostically challenging lesions in man and domestic animals.
The classification scheme of odontogenic neoplasms is largely
based upon the inductive interactions between the odontogenic
epithelium and the mesenchyme. Ameloblastoma is the least differentiated
of the noninductive odontogenic tumors and may cause confusion
and difficulties in diagnosis, especially due to the disparity
between veterinary and human pathological nomenclature. Ameloblastic
fibroma is the least differentiated of the epithelial odontogenic
tumors in which there is inductive mesenchymal change, and the
histologic similarities shared by the tumors make differentiation
difficult.
-
- Regardless of nomenclature, the biological behavior of ameloblastoma
and ameloblastic fibroma is similar. While ameloblastoma may
be more locally invasive, both tumors are characterized by slow,
expansile growth with virtually no tendency for metastasis. Complete
surgical excision carries a good prognosis.
Significant differences in morphology and prevalence of odontogenic
tumors occur among the various domestic species and humans. The
differences may include novel locations of tumors within the
oral cavity as evidenced by the rabbit of this case. The species
variations and differences in tumor nomenclature should be kept
in mind when characterizing odontogenic tumors in domestic animals.
Contributor: Georgetown University, Division of Comparative
Medicine, 3950 Reservoir Road NW, Washington DC 20007.
-
- References:
- 1. Poulet FM, Valentin BA, Summers BA: A survey of epithelial
odontogenic
tumors and cysts in dogs and cats. Vet Path 29:369-380, 1992.
- 2. Gardner DG, Dubielzig RR: Feline inductive odontogenic
tumor (inductive and fibroameloblastoma)-a tumor unique to cats.
J Oral Path Med 24:185-90, 1995.
- 3. Walsh KM, Denholm LJ, Cooper BJ: Epithelial odontogenic
tumours in domestic animals. J Comp Path 97:503-521, 1987.
-
- Case III - 98-2048 (AFIP 2641082)
-
- Signalment: Seven-year-old, intact male, Rottweiler
dog.
-
- History: This dog presented to the referring veterinarian
because of a one month history of polyuria, polydipsia, inappetence
and lethargy. Vaccinations were current. Physical examination
revealed mild jaundice and a 4 mm diameter, raised nodule on
the upper left palpebra. Following laboratory and diagnostic
imaging results (see below), the dog was referred to surgery
for exploratory laparotomy.
-
- Laboratory Results: Diagnostic work-up including thoracic
and abdominal radiographs revealed moderate hepatomegaly. Abdominal
ultrasound revealed complex echo-patterned masses involving the
liver.
-
- CBC abnormalities included: elevated Hct (60.6%, normal 37.0-55.0%);
elevated Hb (20.1 g/dl, normal 12.0-18.0 g/dl); leukocytosis
(36,000/mL; normal 6,000-16,900/mL) of which 92% (33,120/mL)
were granulocytes. A differential count showed 30% neutrophils
(10,800/mL), 2% bands (720/mL), 4% lymphocytes (1,440/mL), 4%
monocytes (1,440/mL), and 60% eosinophils (21,600/mL). A bone
marrow aspirate was not performed.
-
- Serum chemistry abnormalities included markedly elevated
alkaline phosphatase (1251 UL, normal 30-400 UL) and alanine
aminotransferase (161 UL, normal 8-80 UL). Creatinine (1.98 mg/dl,
normal 0.50-1.80 mg/dl), total protein (8.41 g/dl, normal 5.20-8.20
g/dl) and globulin (5.19 g/dl, normal 2.50-4.50 g/dl) were mildly
elevated. The dog was occult heartworm-negative.
-
- Gross Pathology: At surgery, multiple masses were
noted in all liver lobes, and a mass with similar gross appearance
was noted in the right kidney. The specimen submitted to the
surgical biopsy service consisted of a 15 x 13 x 9 cm wedge of
one liver lobe, within which were multiple 2 to 12 cm diameter
raised, firm, tan nodules.
Contributor's Diagnosis and Comments: Liver: T-cell lymphoma
with tissue eosinophilia, hepatocellular cholestasis, portal
fibrosis, and bile duct hyperplasia.
The histologic differential diagnosis for this dog's malignant,
poorly differentiated, discrete cell neoplasm included mastocytoma,
granulocytic sarcoma (chloroma), lymphoma, and myeloproliferative
disorder. Giemsa-stained sections failed to reveal metachromatic
granules within the cytoplasm of the neoplastic cells. Granulocytic
sarcoma was considered an unlikely possibility due to the absence
of eosinophilic myelocytes or other developmental stages, although
it could not be excluded. Immunohistochemical studies validated
for the dog and performed at the Texas Veterinary Medical Diagnostic
Laboratory showed that approximately 60% of the large mononuclear
cells and all of the polymorphonuclear cells within the tumor
stained positively for CD-18, a marker for cells of myeloid and
lymphoid origin. Approximately 40-50% of the large mononuclear
cells also stained positively for CD-3, a marker for T-lymphocytes.
These observations suggested that the tumor was a T-cell lymphoma.
-
- Leukemoid reaction with neutrophilia and a left shift are
documented to occur in the later stages of many cases of canine
and feline lymphoma3 and in a pony with intestinal lymphosarcoma2.
In humans, there are individual case reports of T-cell lymphoma
with peripheral blood eosinophilia1, and a large-cell lymphoma
mimicking granulocytic sarcoma4. In the three human patients
with peripheral blood eosinophilia, bone marrow biopsies were
hypercellular with eosinophilia and myeloid hyperplasia, but
did not contain malignant lymphoid cells. Interestingly, myeloid
malignancies were later identified in the three reported cases.
The patient described in the report of large-cell lymphoma mimicking
granulocytic sarcoma had neither peripheral blood, nor bone marrow
abnormalities. In both human and veterinary patients, a peripheral
blood eosinophil count above 1500/mL is often correlated with
metastasis and signals a poor prognosis
- .
- Eosinophilopoiesis may be stimulated by several cytokines
including interleukin-5 (IL-5), interleukin-3 (IL-3) and granulocyte-macrophage
colony stimulating factor5,6. All of these factors are recognized
to be secreted by T-lymphocytes. It is proposed that the mechanism
for the circulating eosinophilia and intratumoral infiltrate
of numerous mature eosinophils seen in this dog is the release
of one or more of these cytokines by the neoplastic T-cells.
 10x
obj
10x
obj
- Case 6-3. Liver. Large areas of liver parenchyma
are expanded, separated, and replaced by a pleocellular infiltrate.
There is preservation of the major vessels and some bile ducts,
but in the center of this mass there is effacement of hepatic
plates.
 40x
obj
40x
obj
- Case 6-3. Liver. Infiltrating cells include abundant
eosinophils with lesser numbers of large pleomorphic round cells
admixed with fewer small lymphocytes. Occasional large atypical
cells are associated with numerous 2-3u small basophilic bodies
(lymphoglandular bodies?). A residual bile duct is at the lower
left and strip of brown pigment bearing hepatocytes are at the
upper right.
 40x
obj
40x
obj
- Case 6-3 . Immunohistochemical staining for CD3
antigen reveals that positively staining T cells with small to
medium lymphocyte morphologies are scattered throughout the tumor
and admixed with large atypical cells (which do not usually stain).
 40x
obj
40x
obj
- Case 6-3 . Immunohistochemical staining for CD45RA
antigen is positive in large atypical cells bearing one or more
prominant nucleoli, but staining is generally negative in smaller
cells with lymphocyte morphology.
-
- AFIP Diagnosis: Liver: Malignant B-cell lymphoma,
T-cell rich, with tissue eosinophilia, Rottweiler, canine.
-
- Conference Note: This case was studied in consultation
with the Department of Hematopathology.
-
- Most conference participants favored the diagnosis of malignant
lymphoma, with tissue eosinophilia.
- Participants considered an inflammatory process, but the
presence of atypical round cells, effacement of hepatic architecture,
and lack of neutrophils and macrophages support neoplasia. Mast
cell tumor was strongly considered, but Giemsa and toluidine
blue stains did not demonstrate metachromatic cytoplasmic granules
in the atypical cells. The absence of immature cells of the eosinophilic
series argues against a neoplasm of eosinophils.
-
- An immunohistochemical stain for CD45RA, an antigen expressed
by B-cells (and rarely cutaneous T-cell lymphoma cells), stained
many, large, atypical round cells that had small amounts of amphophilic
cytoplasm, large nuclei with finely-stippled chromation, and
multiple, often prominent, nucleoli. CD3, an antigen expressed
on the surface of T-cells (and within the cytoplasm of activated
NK cells), was expressed by many lymphoid cells; however, in
the procedure performed at the AFIP, the cells that stained for
CD3 were small to medium-sized lymphocytes that did not have
clearly atypical features. The large, atypical cells did not
stain for CD3 and did stain for CD45RA (see immunohistochemistry
results on the AFIP Veterinary Pathology website). Both of these
immunohistochemical tests have been validated in dogs. In the
opinions of the Departments of Veterinary Pathology and Hematolymphatic
Pathology, the findings support a malignant B-cell lymphoma with
nonneoplastic T-cell and eosinophil infiltrates. Application
of lymphoid markers to diagnostic cases is a rapidly evolving
field in veterinary pathology. Use of different protocols and
panels will inevitably lead to differing interpretations. Hopefully,
standardized protocols and panels will be developed and accepted.
-
- Humans also develop T-cell rich, B-cell lymphoma. This variant
is classified under the umbrella of diffuse large B-cell lymphoma
based on biological behavior and response to treatment. Plasma
cells and eosinophils are prominent in some human cases. The
morphology of this canine lymphoid tumor has some features in
common with Hodgkin's disease, another variant of lymphoma that
may include large numbers of eosinophils. The defining histologic
feature of Hodgkin's disease in people, the Reed-Sternberg cell,
is not present in the examined sections of liver from this dog.
-
- Various hypotheses have been offered to explain the prominent
T-cell infiltrate within some B-cell lymphomas. Some have postulated
that the T-cell infiltrate is a host immune response to the neoplasm.
Others believe that cytokines secreted by neoplastic B-cells
may act as a chemotactant for T-cells. Alternatively, some have
speculated that the T-cells may be the neoplastic population
and subsequently induce an atypical proliferation of blastic
B-cells. The latter theory, however, is not supported by genotypic
findings. Irrespective of the reason for the presence of the
T-cell infiltrate, these activated lymphocytes are the likely
cause for the attraction of numerous eosinophils.
-
- Contributor: Angell Memorial Animal Hospital, 350
South Huntington Avenue, Boston, MA 02130.
-
- References:
- 1. Abruzzo LV, et al.: T-cell lymphoblastic lymphoma and
eosinophilia associated with subsequent myeloid malignancy. Am
J Surg Path 16:236-245, 1992.
- 2. Duckett WM, Matthews HK: Hypereosinophilia in a horse
with intestinal lymphosarcoma. Can Vet J 38:719-720, 1997.
- 3. Moulton, JE (ed): In: Tumors of Domestic Animals, 3rd
ed., p. 244, University of California Press Ltd., 1990.
- 4. Whitcomb CC, Sternheim WL, Borowitz MJ, Davila E, Byrne
GE Jr: T-cell lymphoma mimicking granulocytic sarcoma. Am J Clin
Path 84:706-763, 1985.
- 5. Rothenberg ME, et al.: Human eosinophils have prolonged
survival, enhanced functional properties and become hypodense
when exposed to human Interleukin-3. J Clin Invest 81:1986-1992,
1988.
- 6. Owen WF, et al.: Interleukin-5 and phenotypically altered
eosinophils in the blood of patients with the idiopathic hypereosinophilic
syndrome. J Exp Med 170:343-348, 1989.
- 7. Kelley LC, Mahaffey EA: Equine malignant lymphomas: Morphologic
and immunohistochemical classification. Vet Pathol 35:241-252,
1998.
- 8. Warnke RA, et al.: Tumors of the lymph nodes and spleen.
In: Atlas of Tumor Pathology, 3rd Series Fascicle 16, Armed Forces
Institute of Pathology, Washington DC, 1995.
-
- Case IV - 556-98 (AFIP 2643249)
-
- Signalment: Three-month-old, female, Domestic Shorthair
cat.
-
- History: The cat presented febrile (103°F) with
a pneumonia that failed to respond to antibiotic treatment. The
cat was subsequently euthanized.
-
- Gross Pathology: The lung was diffusely atelectatic,
and the thoracic cavity contained a large volume of purulent
material. A lung lobe contained an approximately four-centimeter
diameter, multilobulated mass.
-
- Laboratory Results: Feline leukemia virus and feline
immunodeficiency virus tests conducted antemortem were negative.
Purulent material obtained at necropsy yielded pure culture of
Rhodococcus equi.
-
- Contributor's Diagnosis and Comments:
- 1. Lung, pleura: Pleuritis, pyogranulomatous, chronic, severe,
due to Rhodococcus equi.
- 2. Lung: Pneumonia, necropurulent, chronic, focal.
-
- Sections from the submitted lung vary, yet consistently feature
atelectasis accompanied by thickened pleura containing large
numbers of macrophages, neutrophils, lymphocytes, and plasma
cells. Multifocal fibroblasts and collagen accompany the pleural
infiltrates. Sections containing the pleural abscess seen grossly
also contain large amounts of necrotic debris surrounded by similar
pyogranulomatous infiltrates. Several bronchi and bronchioles
contain mucinous material. Several submitted slides contain a
fragment of foreign material consistent with plant origin. Many
pleural macrophages have an eosinophilic granular cytoplasm.
Also submitted is a Brown and Brenn stained section which reveals
intracellular, gram-positive, predominately coccoid forms, although
a few short rod-shaped bacteria are also seen within macrophages.
Rhodococcus equi, previous known as Corynebacterium equi, is
a small, pleomorphic, gram-positive rod found in soil, manure,
and litter. It most commonly causes pneumonia in foals 1-3 months
of age resulting in multiple, sometimes large, abscesses within
lung and lymph nodes. Mortality can be high in younger foals.
While Rhodococcus equi has been isolated from lesions in dogs,
abscesses in cats have been the most commonly reported manifestation
in small animals. Organisms may gain access to the body via a
penetrating wound. Fragments of plant material entrapped within
exudate in this case would be consistent with introduction of
the bacteria from a penetrating wound.
 4x
obj
4x
obj
- Case 6-4. Lung. There is marked compression and
infiltration of alveoli by a cellular infiltrate. Bronchi in
the lower left contains an amphophilic exudate. Pleural connective
tissue in the upper right is coated by a heavy, partly detached
cellular exudate.
 40x
obj
40x
obj
- Case 6-4. Lung, pleura. Exudate covering the
pleura is composed of abundant plump epithelioid macrophages
which occasionally contain variable numbers of 1x3u eosinophilic
bodies interpreted as bacilli. Moderate numbers of neutrophils
and fewer lymphocytes and plasma cells are scattered throughout
this exudate.
-
- AFIP Diagnosis: Lung: Pleuritis, pyogranulomatous,
diffuse, severe, with multifocal pyogranulomatous pneumonia,
diffuse atelectasis, and numerous intrahistiocytic gram-positive
coccobacilli, Domestic Shorthair, feline.
-
- Conference Note: Rhodococcus equi is a gram-positive,
variably acid-fast, facultative intracellular, pleomorphic coccobacillus.
In addition to horses, the organism causes pneumonia occasionally
in cattle, sheep, swine, and infrequently in other species including
dogs and cats. R. equi has been associated with arthritis in
lambs and pyogranulomatous inflammation in the cervical and mandibular
lymph nodes of swine. Cutaneous infections may occur in cats
due to penetrating trauma, and lesions are characterized by localized
swelling with ulceration, fistulas, and purulent drainage that
most commonly affect an extremity. There is a report of the organism
causing pneumonia and pleuritis in a monkey.
-
- Reports of infection with R. equi in cats are uncommon, but
may be increasing in frequency due to concurrent infection with
immunosuppressive viruses, such as feline immunodeficiency virus
and feline leukemia virus. Age is another factor that determines
immune status, especially in people. Though newborns of domestic
species are capable of mounting immune responses at birth, the
reactions in neonatal and perinatal animals are characterized
as primary immune responses, with a considerable lag period and
low concentration of antibodies. Foals between two and four months
are most susceptible to infection, while infection in horses
older than six months is uncommon unless there is concurrent
immunodeficiency. Age may have been a predisposing factor for
infection in this relatively young kitten.
-
- Reports of human infection with R. equi are increasing due
to immunodeficiency caused by HIV infection. Affected humans
often have a history of exposure to horses. The organism, a soil
saprophyte commonly recovered from the manure of herbivores,
causes pneumonia and pulmonary abscesses in affected individuals.
Regardless of the route of infection in animals or people, the
organism may spread via the lymphatics to regional lymph nodes,
and then may disseminate hematogenously to the liver, spleen
and visceral lymph nodes.
-
- In addition to host immunocompetency, several proposed bacterial
virulence factors may predispose animals and humans to infection;
these virulence factors seem to be strain-dependent. While the
organism is susceptible to the bactericidal effects of neutrophils,
virulent strains are able to resist macrophage defenses, establish
residence within the cytoplasm of the macrophage, and replicate.
Proposed virulence factors include the presence of a capsular
polysaccharide, the exoenzyme cholesterol oxidase, cell wall
mycolic acids, and the products encoded by a virulence-associated
plasmid.
-
- Contributor: C. E. Kord Animal Disease Diagnostic
Laboratory, P.O. Box 40627, Melrose Station, Nashville, TN 37204.
-
- References:
- 1. Carter GR and Chengappa MM: Rhodococcus. In: Microbial
Diseases; A
Veterinarian's Guide to Laboratory Diagnosis, 1993, Iowa State
University Press, Ames, IA, pp. 217-219.
- 2. Green CE: Rhodococcus equi infection of cats. In: Infectious
Diseases of the Dog and Cat, CD Green, ed., 1990, WB Saunders,
Philadelphia, pp. 606-607.
- 3. Green CE: Bacterial diseases. In: Textbook of Internal
Medicine, S.J. Ettinger, E.C. Feldman, eds., 4th ed., 1995, WB
Saunders, Philadelphia, p 372.
- 4. Jones PC, Hunt D, and King NW: Diseases caused by bacteria.
In: Veterinary Pathology, 6th ed., Williams and Wilkins, 1997,
Baltimore, MD, p 486.
- 5. Tizard IR: Immunity in the fetus and newborn. In: Veterinary
Immunology: An Introduction, 5th ed., pp. 237-250, WB Saunders
Co., Philadelphia, 1996.
- 6. Hondalus MK: Pathogenesis and virulence of Rhodococcus
equi. Vet Microbiol 56:257-268, 1997.
-
- International Veterinary Pathology Slide Bank:
Laser disc frame #2433, 2497.
-
- Ed Stevens, DVM
Captain, United States Army
Registry of Veterinary Pathology*
Department of Veterinary Pathology
Armed Forces Institute of Pathology
(202)782-2615; DSN: 662-2615
Internet: STEVENSE@afip.osd.mil
-
- * The American Veterinary Medical Association and the American
College of Veterinary Pathologists are co-sponsors of the Registry
of Veterinary Pathology. The C.L. Davis Foundation also provides
substantial support for the Registry.
Return to WSC Case Menu

 2x
obj
2x
obj 20x
obj
20x
obj
 10x
obj
10x
obj
 10x
obj
10x
obj
 40x
obj
40x
obj
 40x
obj
40x
obj
 40x
obj
40x
obj
 4x
obj
4x
obj
 40x
obj
40x
obj